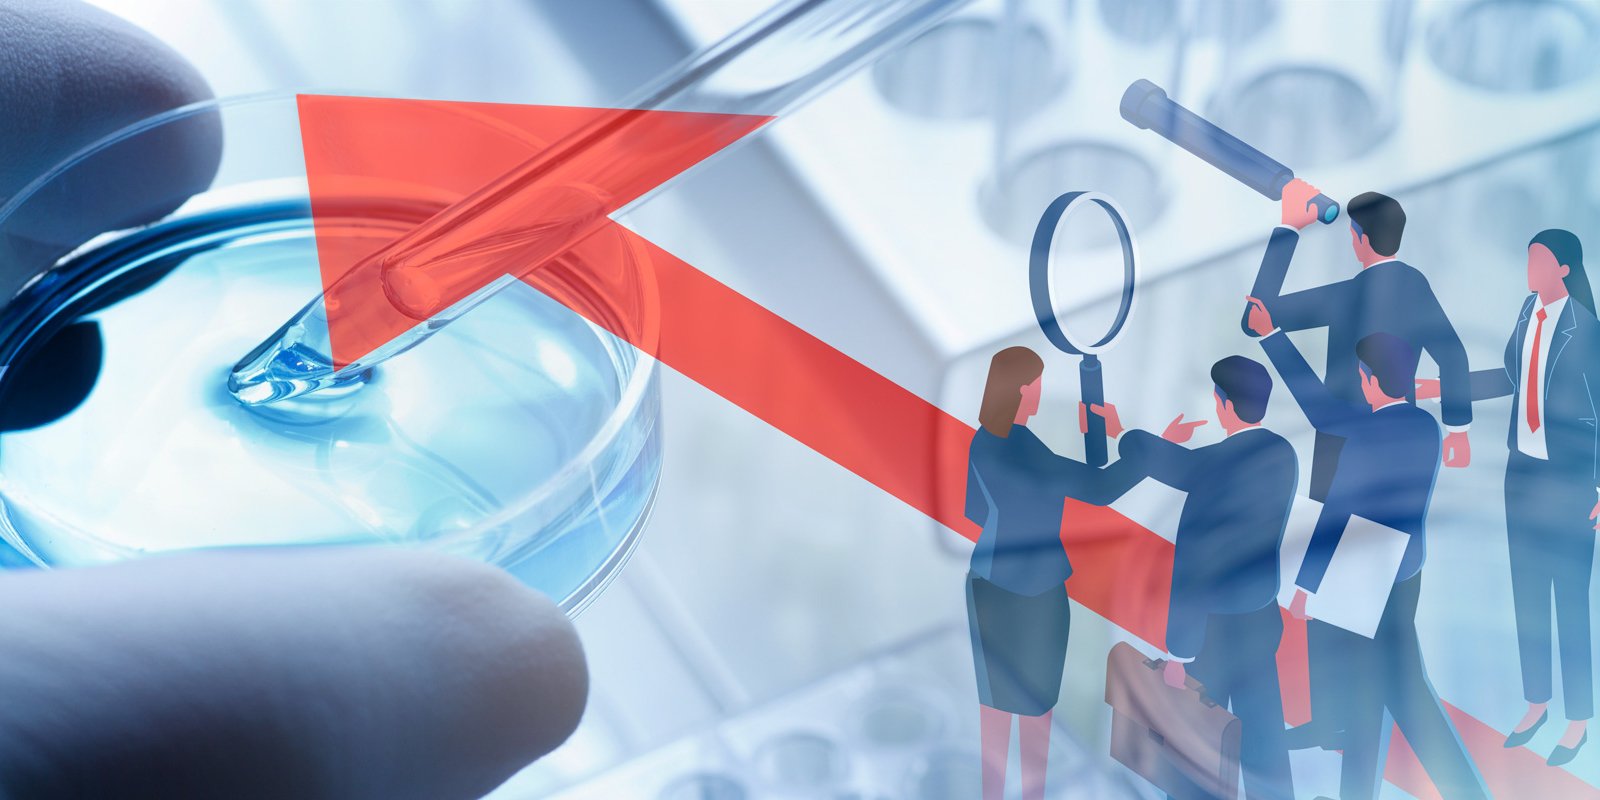

Medicare's Innovation Center Charts New Direction: Part 1 - Providers
The Center for Medicare and Medicaid Innovation ("CMMI") is set to reshape value-based care. In the first of a three-part series highlighting this new direction, this summary is focused on CMMI's efforts regarding health care providers.
On May 13, 2025, CMMI signaled a new direction for value-based care by releasing a white paper, "CMS Innovation Center Strategy to Make America Healthy Again," and producing a webinar with Centers for Medicare & Medicaid Services ("CMS") Administrator Dr. Mehmet Oz and CMMI Director Abe Sutton. This future plan for health care providers emphasizes waivers, benefit enhancement incentives, and preventive care.
Guided by a foundational principal to protect federal taxpayers while advancing three pillars—promoting evidence-based prevention, empowering achievement of health goals, and driving choice and competition for health services—CMMI, in its release, discussed several new priorities and opportunities with particular focus on prevention and value-based systems. Highlights include:
- Focus on lifestyle and nutrition: Rather than emphasizing medical intervention like annual wellness visits, the white paper highlights the utilization of lifestyle and nutrition interventions such as quality nutrition, health counseling, and promotion of exercise, in disease prevention efforts.
- Emphasizing preventive care: CMMI intends to develop new models that allow for care provided by community-based organizations, additional direct patient care options, increased access to traditional prevention methods such as screenings and disease management, and alternative medicines.
- Introduction of new waivers: CMMI discussed a number of new potential waivers for accountable care organizations ("ACOs") and other structures, such as waivers to support predictable cost-sharing and to incentivize preventive care.
- Expanding alternative programs: By both standardizing model design to reduce administrative burdens and expanding the use of advanced shared savings and prospective payments, CMMI seeks to increase the number of providers, especially independent providers, participating in the programs.
- Risk for all providers: CMMI plans to require all alternative payment models to involve downside risk and all providers to bear some financial risk in such models—an ambitious goal, as many ACOs currently participate without risk.
- Abandoning the 2030 ACO goal: According to CMMI Director Sutton, CMMI is departing from the Biden-era goal to have all fee-for-service Medicare beneficiaries in ACOs by 2030.